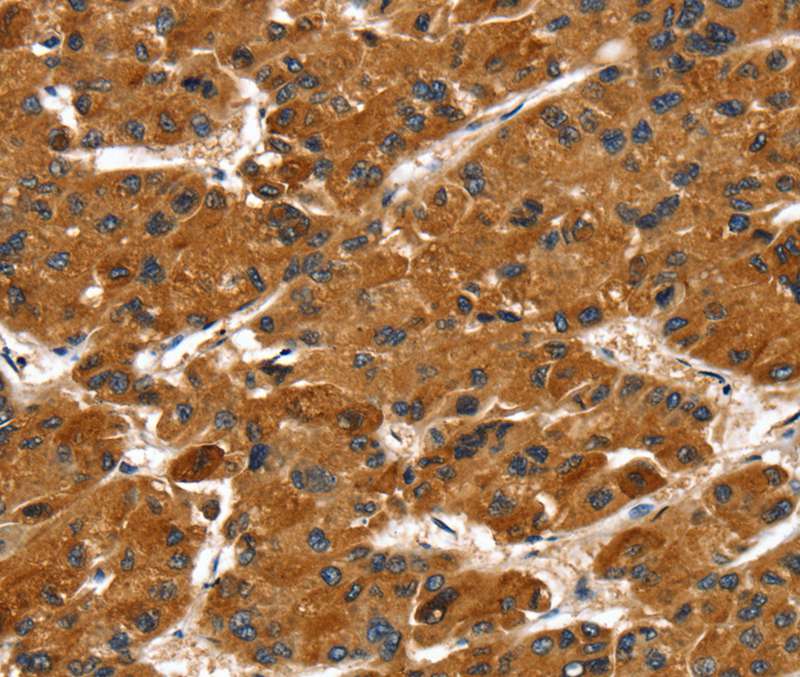
Anti-PTPN5 Antibody

Immunohistochemical staining of human caudate shows moderate cytoplasmic and nuclear positivity in neuronal cells.
Anti-PTPN5 Antibody
HPA031014
ApplicationsImmunoHistoChemistry
Product group Antibodies
ReactivityHuman
TargetPTPN5
Overview
- SupplierAtlas Antibodies
- Product NameAnti-PTPN5 Antibody
- Delivery Days Customer4
- ApplicationsImmunoHistoChemistry
- CertificationResearch Use Only
- ClonalityPolyclonal
- ConjugateUnconjugated
- Gene ID84867
- Target namePTPN5
- Target descriptionprotein tyrosine phosphatase non-receptor type 5
- Target synonymsPTPSTEP, STEP, STEP61, tyrosine-protein phosphatase non-receptor type 5, neural-specific protein-tyrosine phosphatase, protein tyrosine phosphatase, non-receptor type 5 (striatum-enriched), protein-tyrosine phosphatase striatum-enriched, striatal-enriched protein tyrosine phosphatase, striatum-enriched protein-tyrosine phosphatase
- HostRabbit
- IsotypeIgG
- Protein IDP54829
- Protein NameTyrosine-protein phosphatase non-receptor type 5
- Scientific DescriptionRecombinant Protein Epitope Signature Tag (PrEST) antigen sequence
- ReactivityHuman
- Storage Instruction-20°C,2°C to 8°C
- UNSPSC41116161